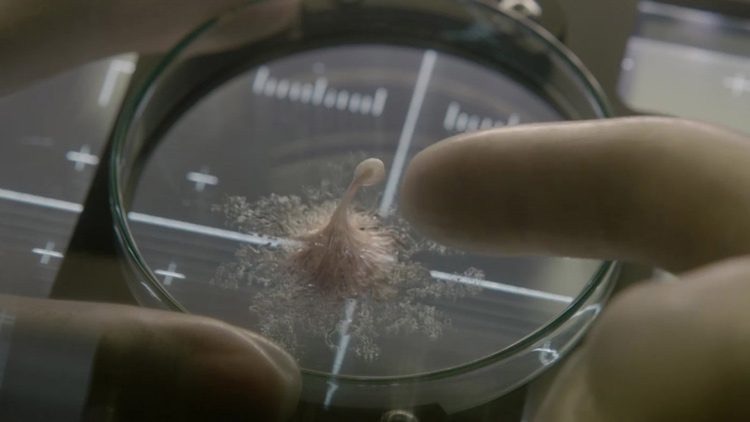

Tener la oportunidad de acompañar a tu sobrino a ver una película de ciencia ficción-terror no tiene precio. Aunque las críticas no sean demasiado buenas, comprobar que el chiquillo se lo ha pasado en grande, dando botes en el asiento, tapándose los ojos cuando se mascaba la tragedia, ha hecho que yo también conectara con la historia y sintiera la tensión.

Sin embargo, él no tiene el mismo recorrido a través del género que su tío, y ni tan solo recuerda si ha visto Alien anteriormente, por ello no ha tenido la sensación de déjà vu que he tenido yo. Life evoca tanto la cinta de Ridley Scott que parece como si le hubieran querido hacer un homenaje. Por ese motivo todo resulta muy predecible, a pesar de alguna que otra sorpresa.

Sin embargo, lo que sí me ha gustado es el diseño del extraterrestre, ya que por una vez no era antropomórfico. Convirtiéndose quizás en el gran protagonista de la historia.


Pero para mí lo mejor han sido las escenas de acción, con picos de alta tensión muy logrados, acompañados de una música que sin unos buenos altavoces no tendría el mismo efecto, y unos buenos efectos visuales al estilo de Gravity. La sensación de que siempre estás en gravedad cero es también un aspecto destacable, incluso el hecho de que no existe arriba o abajo como ocurre en las primeras escenas.

Seguro que no es un título que pase a la historia como su padre Alien, pero tiene sus momentos y para pasar una tarde entretenida está muy bien.